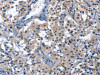
The image on the left is immunohistochemistry of paraffin-embedded Human thyroid cancer tissue using CSB-PA438445 (CDO1 Antibody) at dilution 1/40, on the right is treated with fusion protein. (Original magnification: ×200)

Cusabio Polyclonal Antibodies
CDO1 Antibody | CSB-PA438445
- SKU:
- CSB-PA438445
- Availability:
- 3 to 7 Working Days
Description
CDO1 Antibody | CSB-PA438445 | Cusabio
CDO1 Antibody is Available at Gentaur Genprice with the fastest delivery.
Online Order Payment is possible or send quotation to info@gentaur.com.
Product Type: Polyclonal Antibody
Target Names: CDO1
Aliases: cysteine dioxygenase type 1
Background: CDO1 (cysteine dioxygenase, type I) is a 200 amino acid protein that belongs to the cysteine dioxygenase family and is involved in organosulfur biosynthesis. Existing as a monomer and expressed at high levels in liver and placenta and at lower levels in brain, pancreas and heart, CDO1 functions as a dioxygenase that uses iron and zinc as cofactors to catalyze the conversion of L-cysteine and oxygen to 3-sulfinoalanine.
Isotype: IgG
Conjugate: Non-conjugated
Clonality: Polyclonal
Uniport ID: Q16878
Host Species: Rabbit
Species Reactivity: Human, Mouse, Rat
Immunogen: Fusion protein of human CDO1
Immunogen Species: Human
Applications: ELISA, IHC
Tested Applications: ELISA, IHC;ELISA:1:1000-1:2000, IHC:1:25-1:100
Purification Method: Antigen affinity purification
Dilution Ratio1: ELISA:1:1000-1:2000
Dilution Ratio2: IHC:1:25-1:100
Dilution Ratio3:
Dilution Ratio4:
Dilution Ratio5:
Dilution Ratio6:
Buffer: -20°C, pH7.4 PBS, 0.05% NaN3, 40% Glycerol
Form: Liquid
Storage: Upon receipt, store at -20°C or -80°C. Avoid repeated freeze.
Initial Research Areas: Signal Transduction
Research Areas: Metabolism;Signal transduction